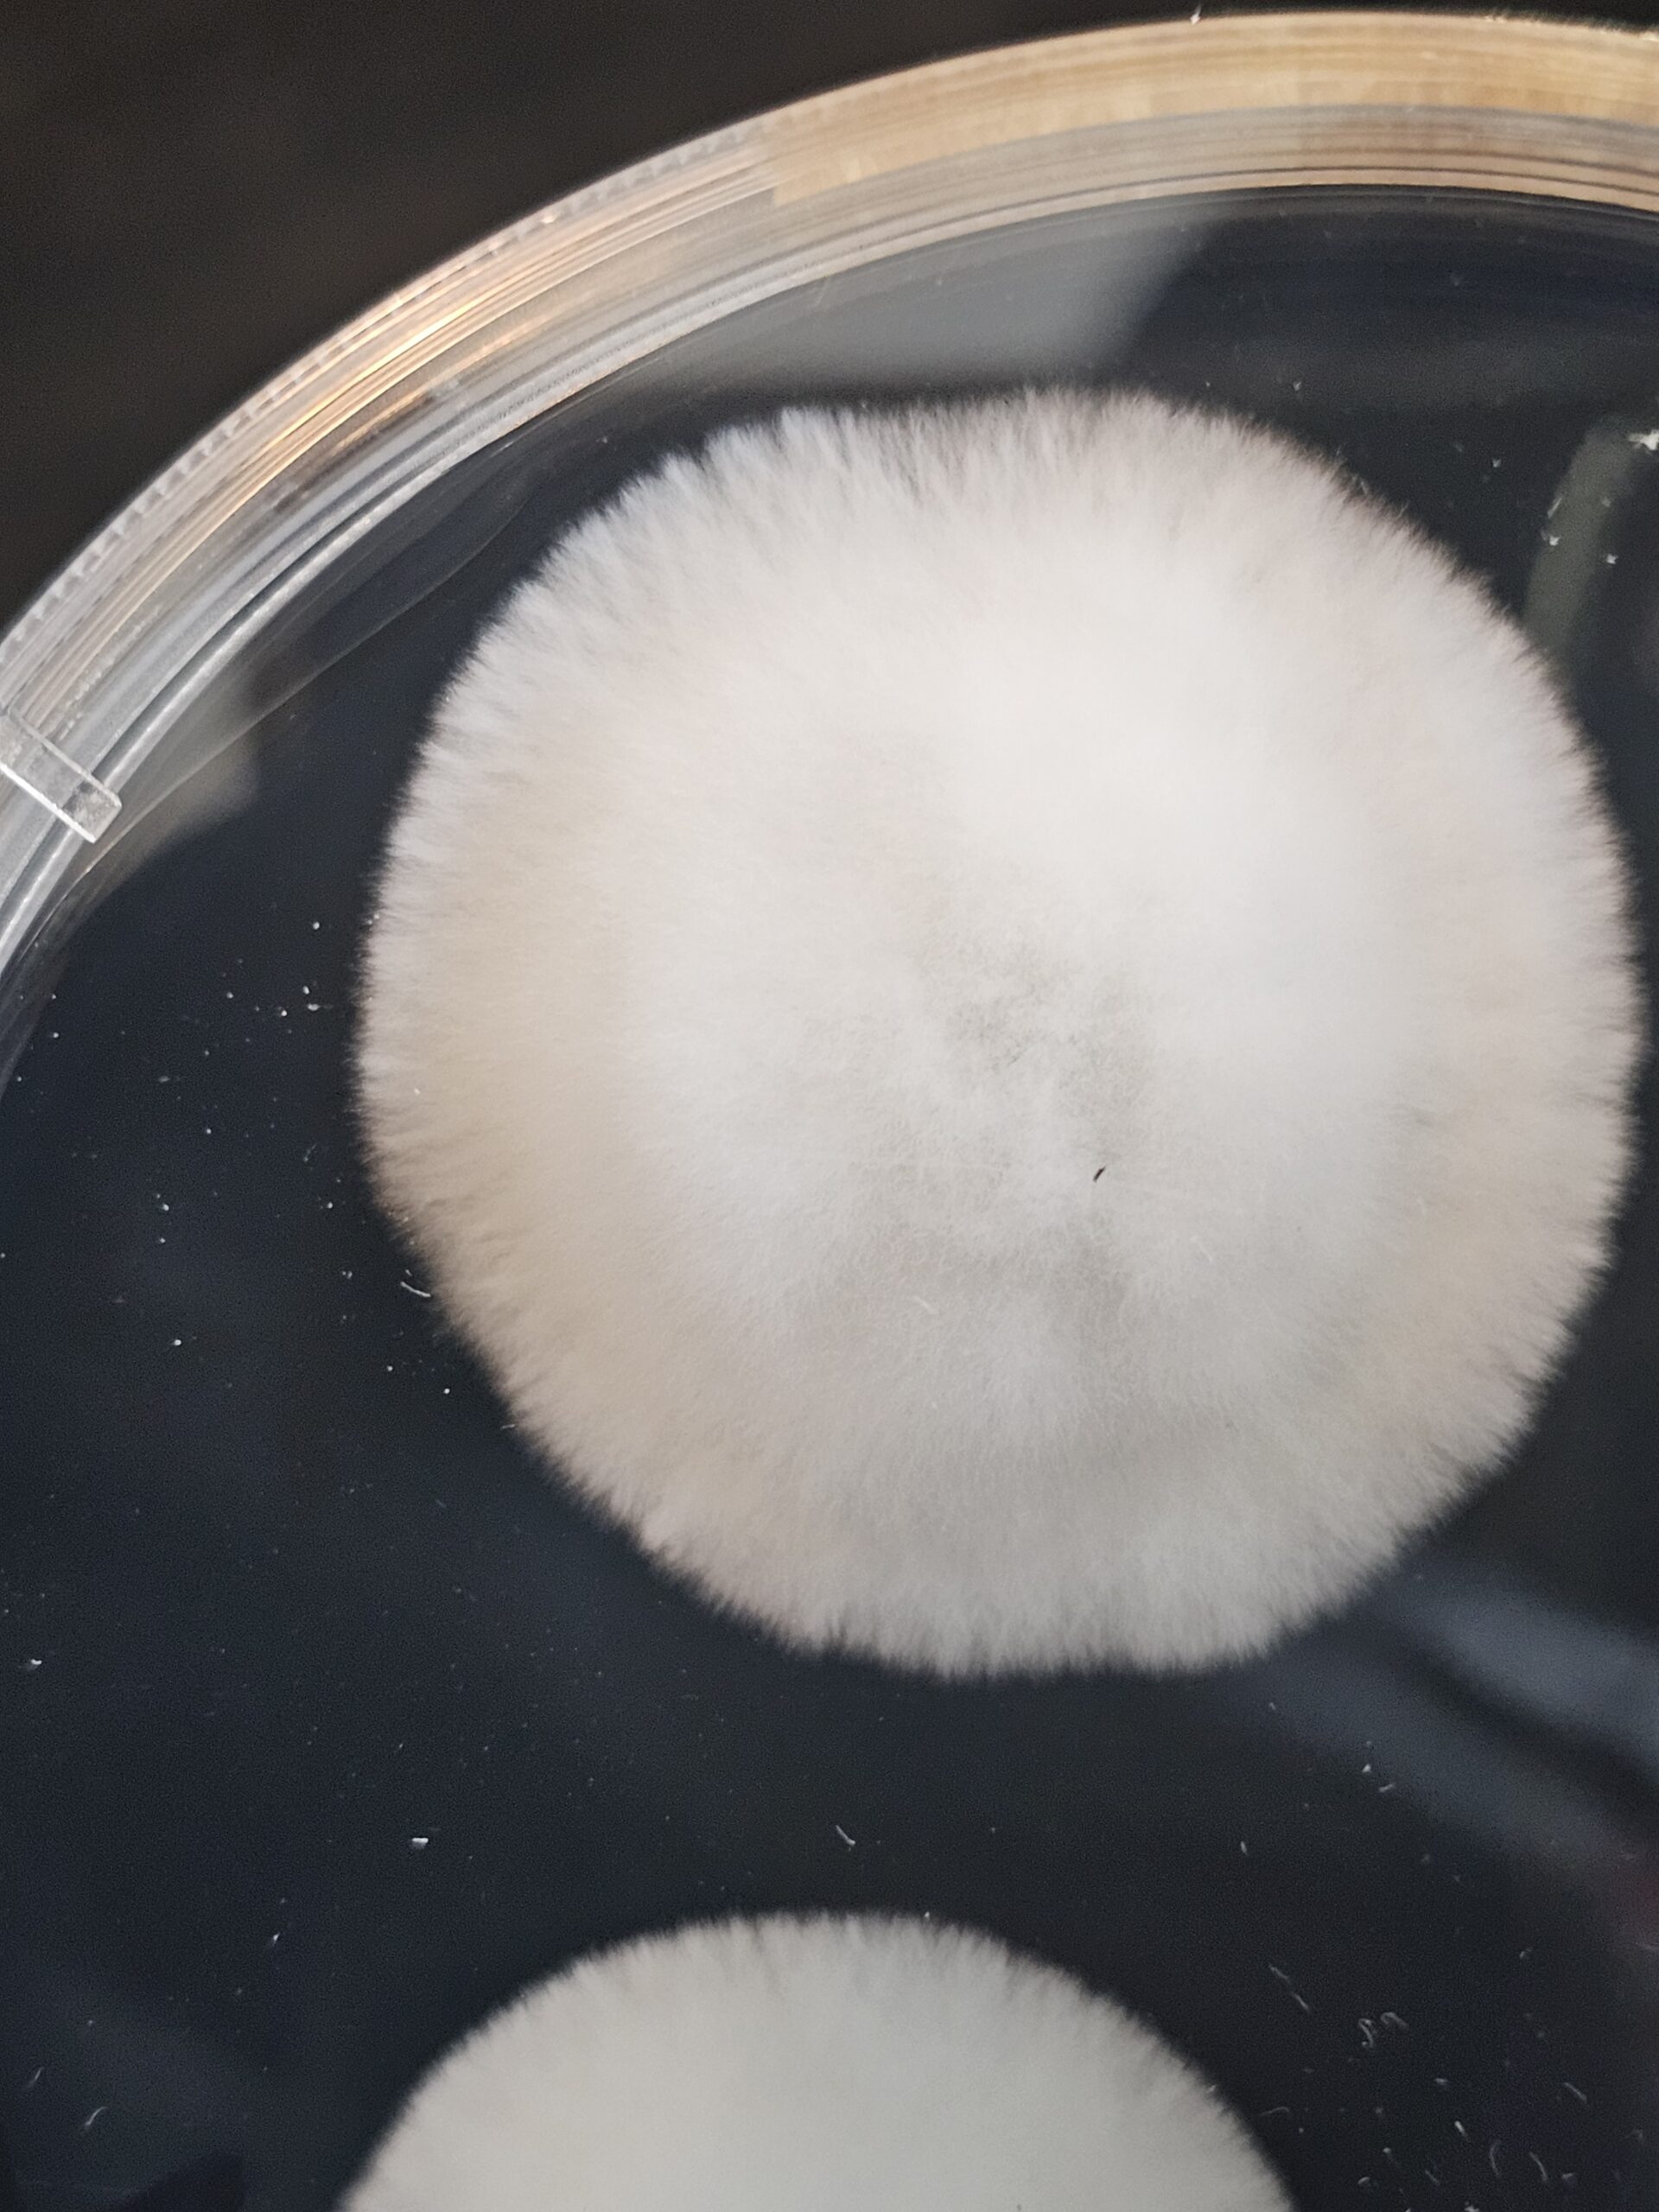
IceBilly Research Plate - Image 2
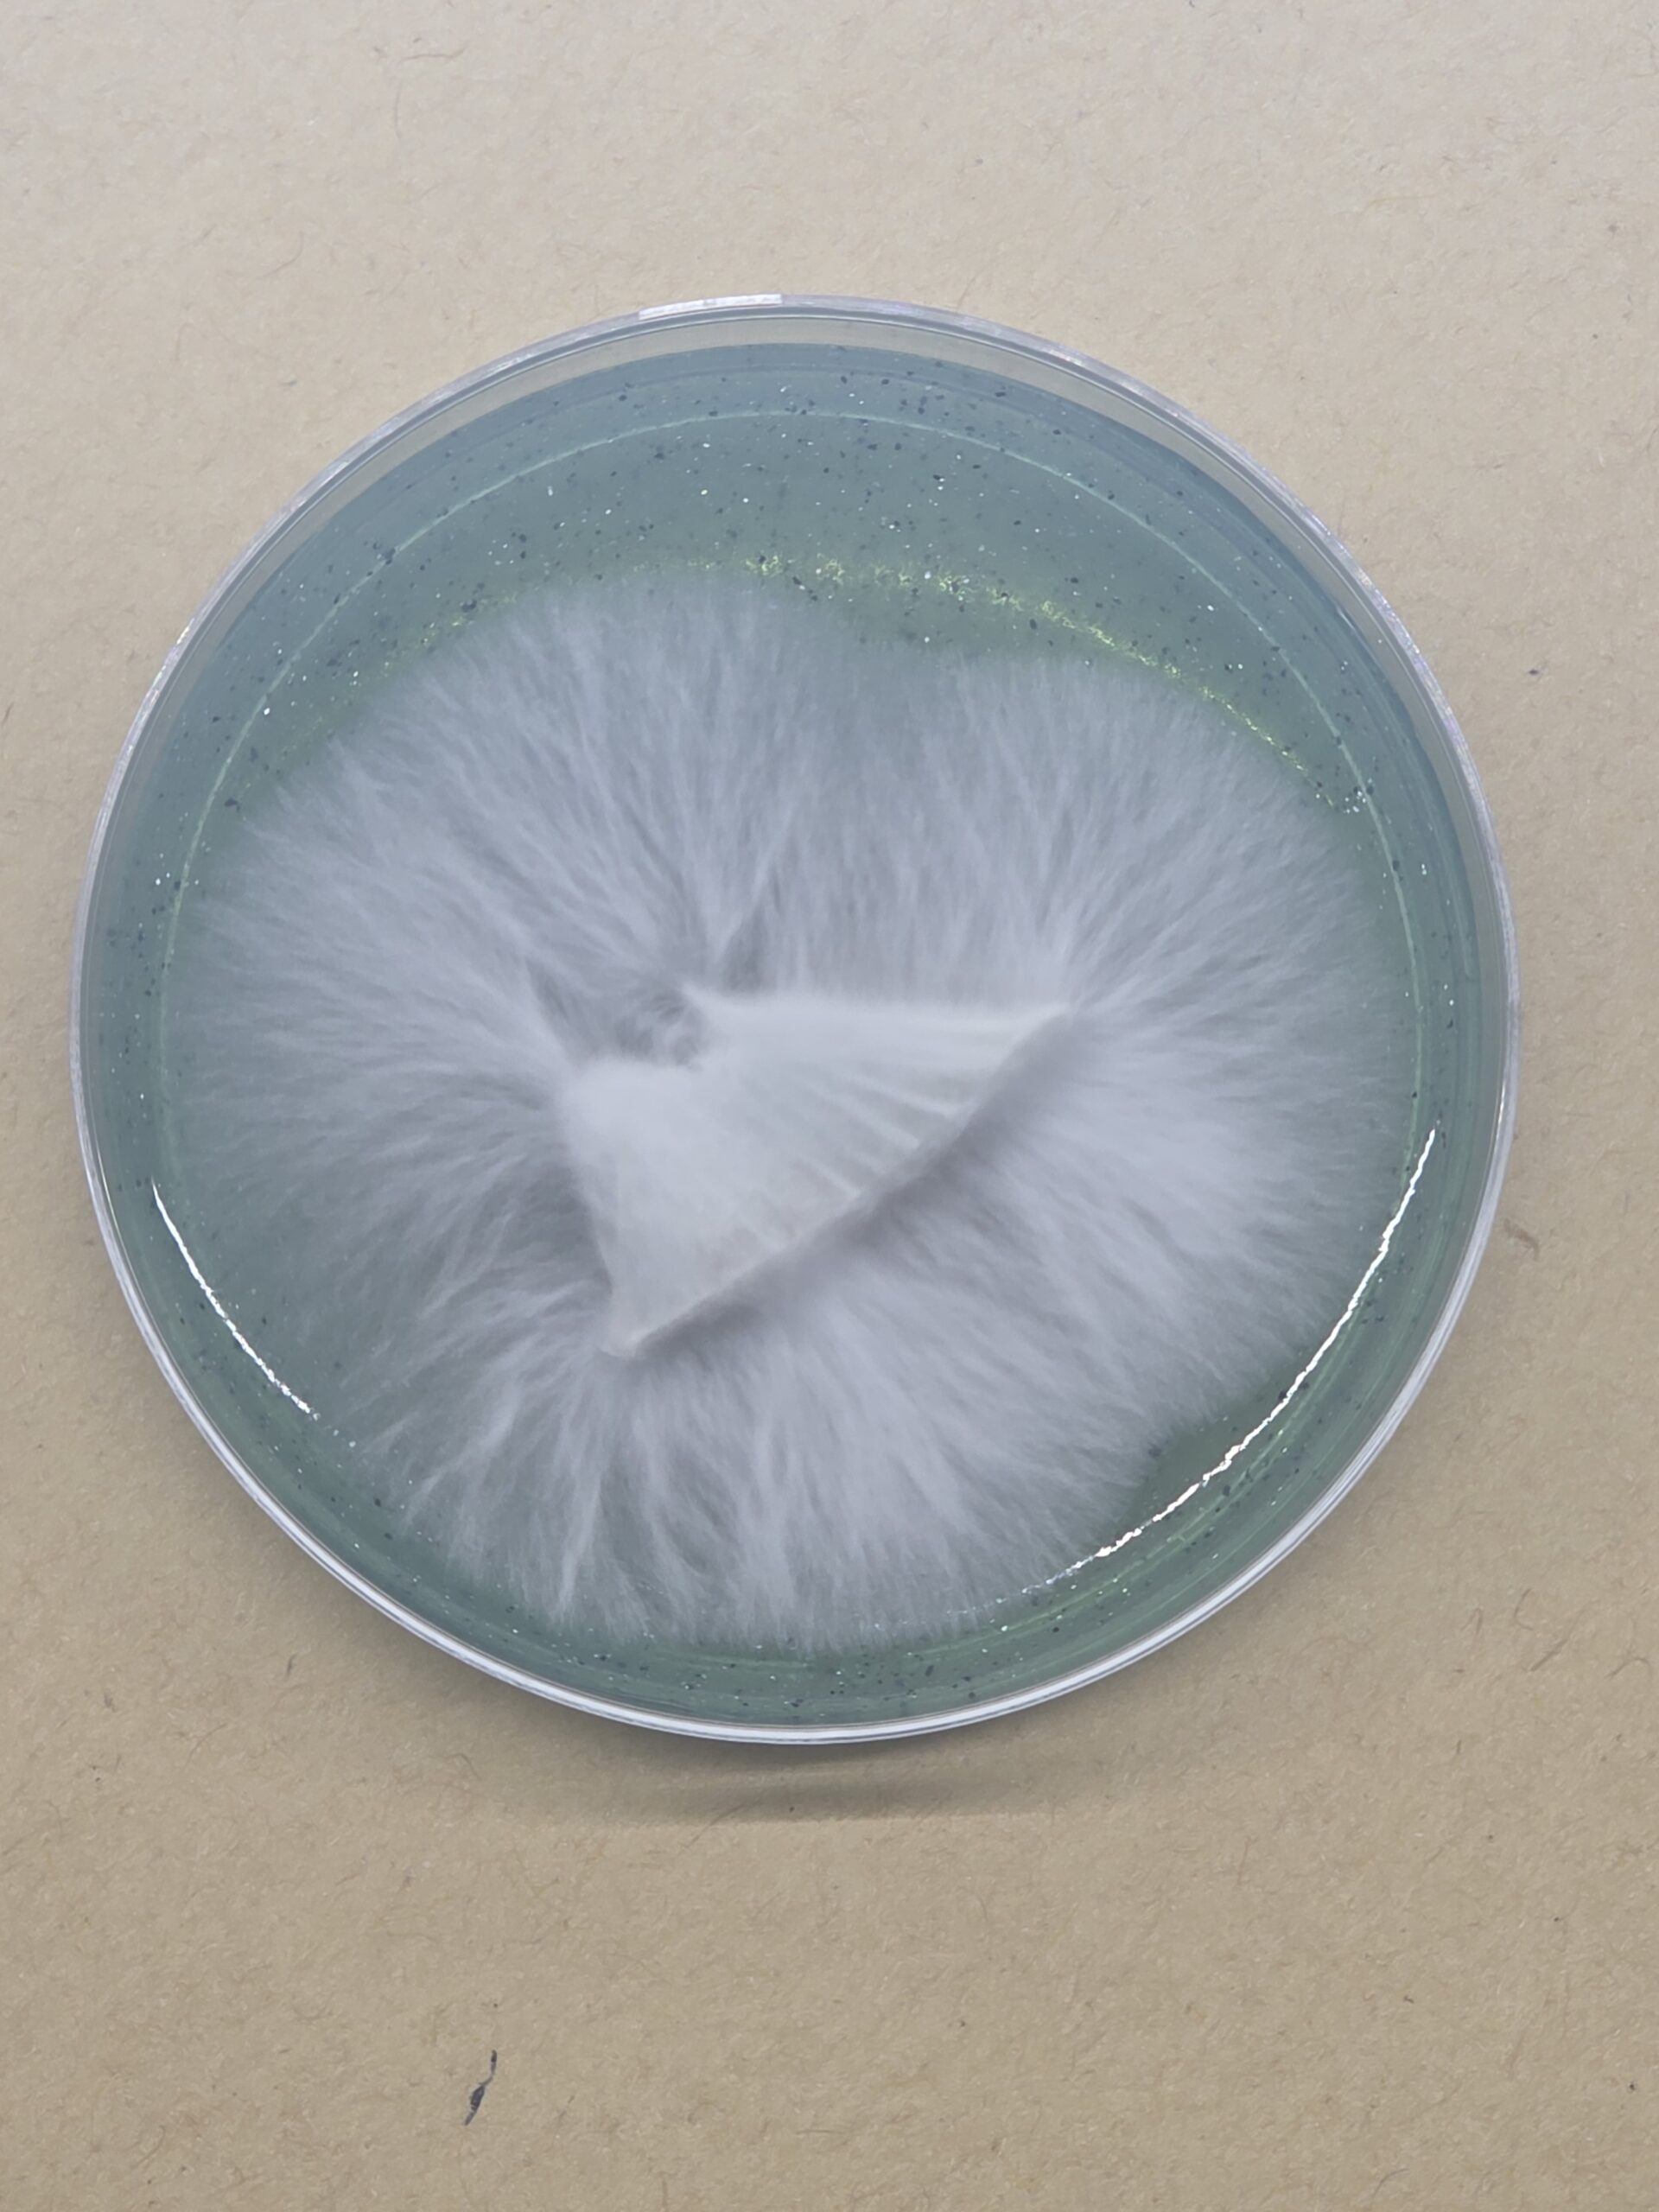
IceBilly Research Plate - Image 4

Only logged in customers who have purchased this product may leave a review.
MICoFroots
Actives, Cultures
IceBilly Research Plate
$20.00
Hybrid cross of Hillbilly Pumpkin x Iceberg by Curt Mellein.
Research Plates are 60mm x 15mm and use 1 of 3 in-house agar recipes rigorously tested for optimal mycelium growth. All Research Plates are made to order and can take up to 10 days before it is ready to ship. Any quality issue with the plate(s), you have 10 days from the time of package delivery to contact me, with photos, for replacement(s). Replacement plates can take up to 10 days to be ready to ship as they are made to order as well. *Rhizomorphic growth is not guaranteed for every strain/plate. See pics for reference.
Units Sold: 0
Active genetics for mycologists of every experience level! We’re here to provide the best quality cultures, spores and supplies on the market!
Shipping costs
| Shipping from | United States (US) |
| Within United States (US) | $10.00 |
| Outside United States (US) | $40.00 |
National Shipping Details
| Maximum shipping charge per order | $10.00 |
| Free shipping if the order spend is over | $100.01 |
International Shipping Details
| Maximum shipping charge per order | $40.00 |

Reviews
There are no reviews yet.